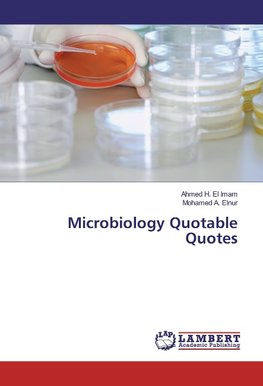
Microbiology Quotable Quotes

-
 Anglický jazyk
Anglický jazyk
Microbiology Quotable Quotes
Autor: Ahmed H. El Imam
Microbiology Quotable Quotes summarize, organize and simplify the fundamental information covering the general and systemic microbiology. This Quotable Quotes is of great interest, designed in a way to make the information more accessible, clear and uniform,... Viac o knihe
Na objednávku
60.12 €
bežná cena: 66.80 €
O knihe
Microbiology Quotable Quotes summarize, organize and simplify the fundamental information covering the general and systemic microbiology. This Quotable Quotes is of great interest, designed in a way to make the information more accessible, clear and uniform, also several efforts have been made to improve the text readability, all students, post-graduate medical practitioners, scientists and healthcare professionals can gain knowledge with feeble effort. This book has been written primarily for updating, reorganizing, and refocusing on bacterial, viral and parasitological diseases, section one covered the basic microbiology concepts and section two quote the precise details aspects of various microbiological diseases. The book explores how the Quotable Quotes can better enlist the essential tips and fact sheet on disease and its pathogenesis, epidemiology, diagnosis, control and treatment, looking forward for early diagnosis, prompt treatment, control and future eradication.
- Vydavateľstvo: LAP LAMBERT Academic Publishing
- Rok vydania: 2016
- Formát: Paperback
- Rozmer: 220 x 150 mm
- Jazyk: Anglický jazyk
- ISBN: 9783659903939












